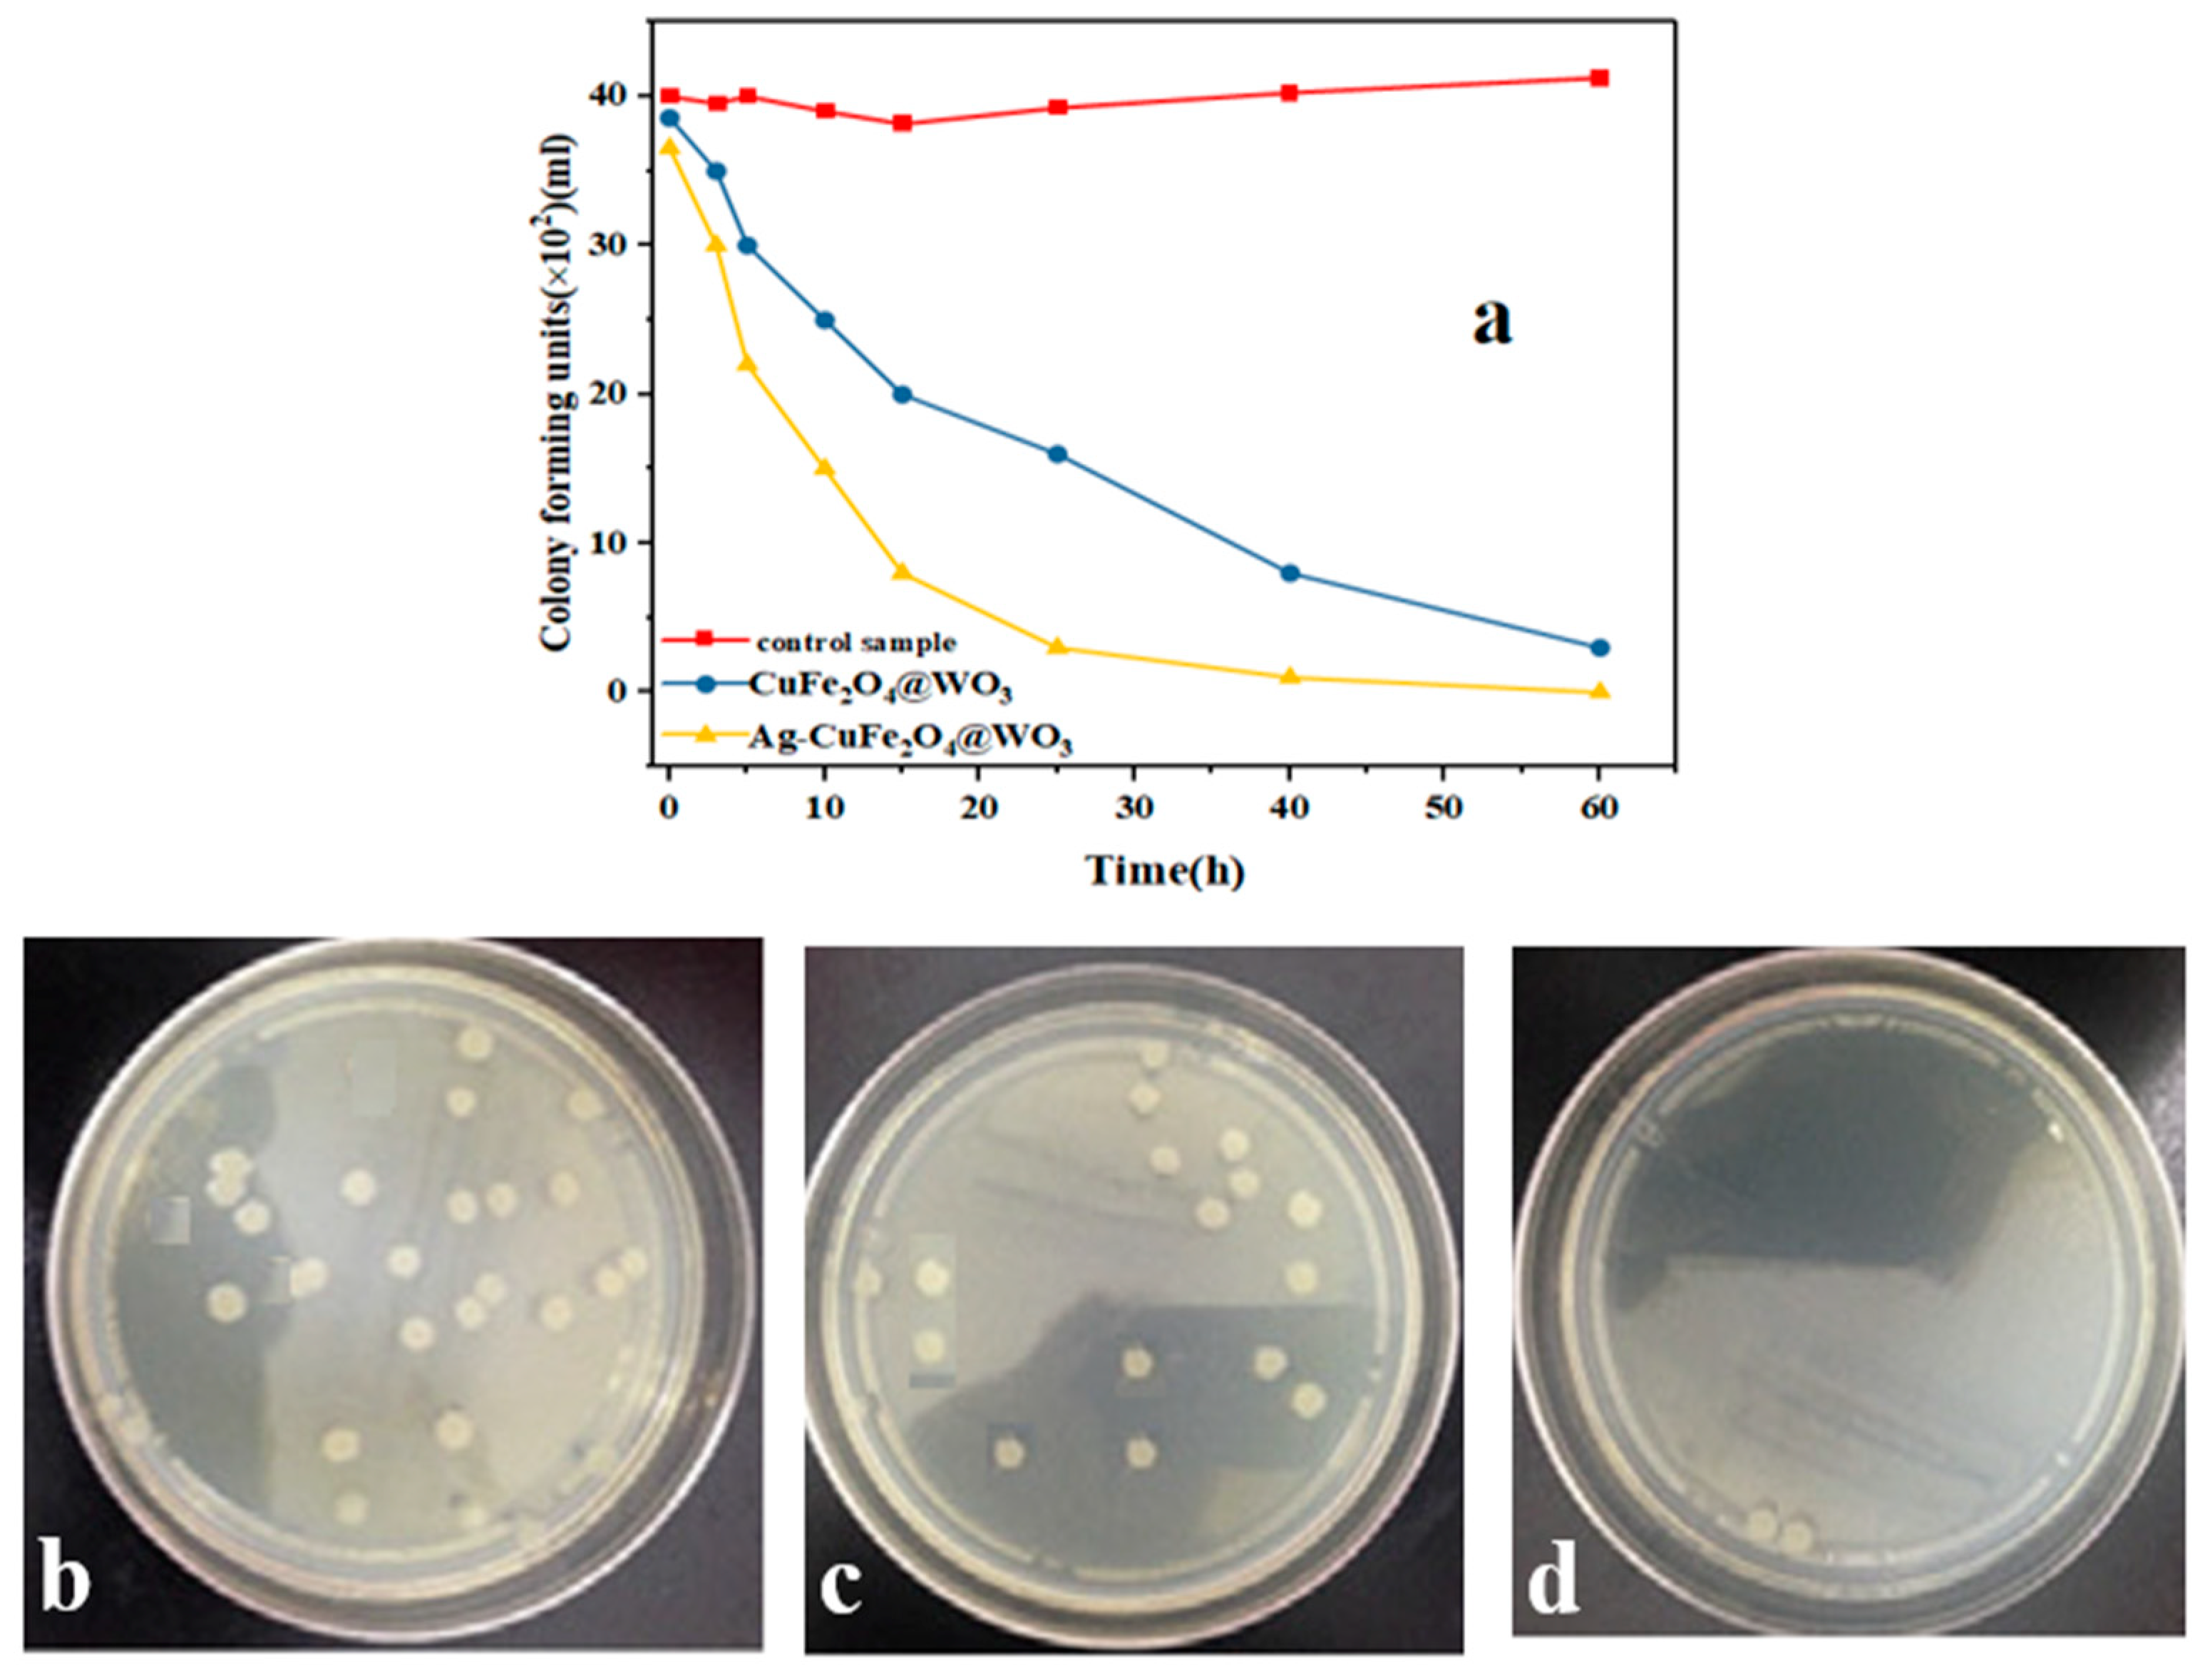
Nanomaterials 11 00298 g010 Nanomaterials 11 00298 g010

Photocatalytic and Antibacterial Properties of Ag-CuFe2O4@WO3 Magnetic Nanocomposite
Abstract
1. Introduction
2. Materials and Methods
2.1. Materials
2.2. Synthesis of the WO3 Nanoparticles
2.3. Synthesis of the CuFe2O4@WO3 Nanoparticles
2.4. Synthesis of the Ag-CuFe2O4@WO3 Nanoparticles
2.5. Characterization of the Nanoparticles
2.6. Photodegradation Tests
2.7. Antibacterial Efficiency Tests
3. Results and Discussion
3.1. Morphology and Size of the Nanoparticles
3.2. Crystallinity of the Nanoparticles
3.3. Elemental Analysis of the Nanoparticles
3.4. Magnetic Properties of the Nanoparticles
3.5. Surface Chemistry of the Nanoparticles
3.6. Surface Chemical Composition of the Nanoparticles
3.7. Band Gap Energy and Optical Activity of the Nanoparticles
3.8. Electron Transfer Ability of the Nanoparticles
3.9. Thermal Stability of the Nanoparticles
3.10. Surface Porosity of the Nanoparticles
3.11. Effect of Adsorption and Photolysis
3.12. Photodegradation Efficiency
3.12.1. Effect of pH
3.12.2. Effect of Initial Drug Concentration
3.12.3. Effect of the Photocatalyst Dosage
3.12.4. Photodegradation Kinetics
3.12.5. Effect of H2O2 Dosage
3.12.6. Effect of Inorganic Anions
3.13. Stability and Reuse of the Photocatalyst
3.14. Photodegradation Mechanism
3.15. Electron Paramagnetic Resonance (EPR)
3.16. Antibacterial Properties
4. Conclusions
Author Contributions
Funding
Data Availability Statement
Acknowledgments
Conflicts of Interest
References
- Yazdani, A.; Sayadi, M.H. Sonochemical degradation of azithromycin in aqueous solution. Environ. Heal. Eng. Manag. 2018, 5, 85–92. [Google Scholar] [CrossRef]
- Yazdi, M.; Sayadi, M.H.; Farsad, F. Removal of penicillin in aqueous solution using chlorella vulgaris and spirulina platensis from hospital wastewater. Desalin. Water Treat. 2018, 123, 315–320. [Google Scholar] [CrossRef]
- Ahmadpour, N.; Sayadi, M.H.; Sobhani, S.; Hajiani, M. Photocatalytic degradation of model pharmaceutical pollutant by novel magnetic TiO2@ZnFe2O4/Pd nanocomposite with enhanced photocatalytic activity and stability under solar light irradiation. J. Environ. Manage. 2020, 271, 110964. [Google Scholar] [CrossRef] [PubMed]
- Koltsakidou, A.; Antonopoulou, M.; Εvgenidou, Ε.; Konstantinou, I.; Lambropoulou, D. A comparative study on the photo-catalytic degradation of Cytarabine anticancer drug under Fe3+/H2O2, Fe3+/S2O82−, and [Fe(C2O4)3]3−/H2O2 processes. Kinetics, identification, and in silico toxicity assessment of generated transforma. Environ. Sci. Pollut. Res. 2019, 26, 7772–7784. [Google Scholar] [CrossRef]
- Zhang, L.; Wu, Z.; Chen, L.; Zhang, L.; Li, X.; Xu, H.; Wang, H.; Zhu, G. Preparation of magnetic Fe3O4/TiO2/Ag composite microspheres with enhanced photocatalytic activity. Solid State Sci. 2016, 52, 42–48. [Google Scholar] [CrossRef]
- Molinari, R.; Caruso, A.; Argurio, P.; Poerio, T. Degradation of the drugs Gemfibrozil and Tamoxifen in pressurized and de-pressurized membrane photoreactors using suspended polycrystalline TiO2 as catalyst. J. Memb. Sci. 2008, 319, 54–63. [Google Scholar] [CrossRef]
- Knoop, O.; Woermann, M.; Lutze, H.V.; Sures, B.; Schmidt, T.C. Ecotoxicological effects prior to and after the ozonation of tamoxifen. J. Hazard. Mater. 2018, 358, 286–293. [Google Scholar] [CrossRef]
- Ganzenko, O.; Oturan, N.; Sirés, I.; Huguenot, D.; van Hullebusch, E.D.; Esposito, G.; Oturan, M.A. Fast and complete removal of the 5-fluorouracil drug from water by electro-Fenton oxidation. Environ. Chem. Lett. 2018, 16, 281–286. [Google Scholar] [CrossRef]
- Homaeigohar, S. The nanosized dye adsorbents for water treatment. Nanomaterials 2020, 10, 295. [Google Scholar] [CrossRef]
- Ghadimi, M.; Zangenehtabar, S.; Homaeigohar, S. An Overview of the Water Remediation Potential of Nanocomposite and Their Ecotoxicological Impacts. Water 2020, 12, 1150. [Google Scholar] [CrossRef]
- Homaeigohar, S.; Mahdavi, H.; Elbahri, M. Extraordinarily water permeable sol–gel formed nanocomposite nanofibrous membranes. Colloid. Interface Sci. 2012, 366, 51–56. [Google Scholar] [CrossRef] [PubMed]
- Mondal, S.K.; Saha, A.K.; Sinha, A. Removal of ciprofloxacin using modified advanced oxidation processes: Kinetics, pathways and process optimization. J. Clean. Prod. 2018, 171, 1203–1214. [Google Scholar] [CrossRef]
- Bahmani, M.; Dashtian, K.; Mowla, D.; Esmaeilzadeh, F.; Ghaedi, M. UiO-66(Ti)-Fe3O4-WO3 photocatalyst for efficient ammonia degradation from wastewater into continuous flow-loop thin film slurry flat-plate photoreactor. J. Hazard. Mater. 2020, 393, 122360. [Google Scholar] [CrossRef] [PubMed]
- Santhosh, C.; Velmurugan, V.; Jacob, G.; Jeong, S.K.; Grace, A.N.; Bhatnagar, A. Role of nanomaterials in water treatment applications: A review. Chem. Eng. J. 2016, 306, 1116–1137. [Google Scholar] [CrossRef]
- Bhattacharyya, A.; Kawi, S.; Ray, M. Photocatalytic degradation of orange II by TiO2 catalysts supported on adsorbents. Catal. Today 2004, 98, 431–439. [Google Scholar] [CrossRef]
- Gao, B.; Yap, P.S.; Lim, T.M.; Lim, T.-T. Adsorption-photocatalytic degradation of Acid Red 88 by supported TiO2: Effect of activated carbon support and aqueous anions. Chem. Eng. J. 2011, 171, 1098–1107. [Google Scholar] [CrossRef]
- Chen, H.; Xiong, X.; Hao, L.; Zhang, X.; Xu, Y. Improved visible light photocatalytic activity of WO3 through CuWO4 for phenol degradation. Appl. Surf. Sci. 2016, 389, 491–495. [Google Scholar] [CrossRef]
- Peng, H.; Ouyang, J.; Peng, Y. A simple approach for the synthesis of bi-functional Fe3O4@WO3−x core–shell nanoparticles with magnetic-microwave to heat responsive properties. Inorg. Chem. Commun. 2017, 84, 138–143. [Google Scholar] [CrossRef]
- Visa, M.; Bogatu, C.; Duta, A. Tungsten oxide—fly ash oxide composites in adsorption and photocatalysis. J. Hazard. Mater. 2015, 289, 244–256. [Google Scholar] [CrossRef]
- Bai, S.; Zhang, K.; Sun, J.; Luo, R.; Li, D.; Chen, A. Surface decoration of WO3 architectures with Fe2O3 nanoparticles for visible-light-driven photocatalysis. CrystEngComm 2014, 16, 3289–3295. [Google Scholar] [CrossRef]
- Kim, J.H.; Jang, Y.J.; Kim, J.H.; Jang, J.W.; Choi, S.H.; Lee, J.S. Defective ZnFe2O4 nanorods with oxygen vacancy for photoelectrochemical water splitting. Nanoscale 2015, 7, 19144–19151. [Google Scholar] [CrossRef] [PubMed]
- Ahmadpour, N.; Sayadi, M.H.; Sobhani, S.; Hajiani, M. A potential natural solar light active photocatalyst using magnetic ZnFe2O4@TiO2/Cu nanocomposite as a high performance and recyclable platform for degradation of naproxen from aqueous solution. J. Clean. Prod. 2020, 268, 122023. [Google Scholar] [CrossRef]
- Priyadharsan, A.; Vasanthakumar, V.; Shanavas, S.; Karthikeyan, S.; Anbarasan, P.M. Crumpled sheet like graphene based WO 3-Fe2O3 nanocomposites for enhanced charge transfer and solar photocatalysts for environmental remediation. Appl. Surf. Sci. 2019, 470, 114–128. [Google Scholar] [CrossRef]
- Atacan, K.; Güy, N.; Çakar, S. Preparation and antibacterial activity of solvothermal synthesized ZnFe2O4/Ag-TiO2 nanocomposite. Sak. Univ. J. Sci. 2018, 22, 1. [Google Scholar] [CrossRef]
- Maicu, M.; Hidalgo, M.C.; Colón, G.; Navío, J.A. Comparative study of the photodeposition of Pt, Au and Pd on pre-sulphated TiO2 for the photocatalytic decomposition of phenol. Photochem. Photobiol. A Chem. 2011, 217, 275–283. [Google Scholar] [CrossRef]
- He, X.; Cai, Y.; Zhang, H.; Liang, C. Photocatalytic degradation of organic pollutants with Ag decorated free-standing TiO2 nanotube arrays and interface electrochemical response. J. Mater. Chem. 2011, 21, 475–480. [Google Scholar] [CrossRef]
- Lima, M.S.; Cruz-Filho, J.F.; Noleto, L.F.G.; Silva, L.J.; Costa, T.M.S.; Luz, G.E. Synthesis, characterization and catalytic activity of Fe3O4@WO3/SBA-15 on photodegradation of the acid dichlorophenoxyacetic (2,4-D) under UV irradiation. J. Environ. Chem. Eng. 2020, 8, 104145. [Google Scholar] [CrossRef]
- Liu, Y.; He, H.; Li, J.; Li, W.; Yang, Y.; Li, Y.; Chen, Q. Preparation and enhanced photoelectrochemical performance of a p-n heterojunction CuFe2O4/WO3 nanocomposite film. RSC Adv. 2015, 5, 99378–99384. [Google Scholar] [CrossRef]
- Tseng, W.J.; Chuang, Y.C.; Chen, Y.A. Mesoporous Fe3O4@Ag@TiO2 nanocomposite particles for magnetically recyclable photocatalysis and bactericide. Adv. Powder Technol. 2018, 29, 664–671. [Google Scholar] [CrossRef]
- Ahmadpour, N.; Sayadi, M.H.; Verma, A.; Mansouri, B. Ultrasonic degradation of ibuprofen from the aqueous solution in the presence of titanium dioxide nanoparticles/hydrogen peroxide. Desalin. Water Treat. 2019, 145, 291–299. [Google Scholar] [CrossRef]
- Lin, W.C.; Chen, C.N.; Tseng, T.T.; Wei, M.H.; Hsieh, J.H.; Tseng, W.J. Micellar layer-by-layer synthesis of TiO2/Ag hybrid particles for bactericidal and photocatalytic activities. J. Eur. Ceram. Soc. 2010, 30, 2849–2857. [Google Scholar] [CrossRef]
- Yin, L.; Chen, D.; Feng, M.; Ge, L.; Yang, D.; Song, Z.; Fan, B.; Zhang, R.; Shao, G. Hierarchical Fe2O3@WO3 nanostructures with ultrahigh specific surface areas: Microwave-assisted synthesis and enhanced H2S-sensing performance. RSC Adv. 2015, 5, 328–337. [Google Scholar] [CrossRef]
- Fan, H.; Chen, D.; Ai, X.; Han, S.; Wei, M.; Yang, L.; Liu, H.; Yang, J. Mesoporous TiO2 coated ZnFe2O4 nanocomposite loading on activated fly ash cenosphere for visible light photocatalysis. RSC Adv. 2018, 8, 1398–1406. [Google Scholar] [CrossRef]
- Batoo, K.M.; Ansari, M.S. Low temperature-fired Ni-Cu-Zn ferrite nanoparticles through auto-combustion method for multilayer chip inductor applications. Nanoscale Res. Lett. 2012, 7, 112. [Google Scholar] [CrossRef] [PubMed]
- Senthil, R.A.; Priya, A.; Theerthagiri, J.; Selvi, A.; Nithyadharseni, P.; Madhavan, J. Facile synthesis of α-Fe2O3/WO3 composite with an enhanced photocatalytic and photo-electrochemical performance. Ionics Kiel. 2018, 24, 3673–3684. [Google Scholar] [CrossRef]
- Chandrika, M.; Ravindra, A.V.; Rajesh, C.; Ramarao, S.D.; Ju, S. Studies on structural and optical properties of nano ZnFe2O4 and ZnFe2O4-TiO2 composite synthesized by co-precipitation route. Mater. Chem. Phys. 2019, 230, 107–113. [Google Scholar] [CrossRef]
- Aslam, I.; Cao, C.; Tanveer, M.; Farooq, M.H.; Khan, W.S.; Tahir, M.; Idrees, F.; Khalid, S. A novel Z-scheme WO3/CdWO4 photocatalyst with enhanced visible-light photocatalytic activity for the degradation of organic pollutants. RSC Adv. 2015, 5, 6019–6026. [Google Scholar] [CrossRef]
- Preetha, D.; Arun, R.; Kumari, P.; Aarti, C. Synthesis and characterization of silver nanoparticles using cannonball leaves and their cytotoxic activity against Mcf-7 cell line. J. Nanotechnol. 2013, 2013, 1–5. [Google Scholar]
- Jia, X.; Dai, R.; Lian, D.; Han, S.; Wu, X.; Song, H. Facile synthesis and enhanced magnetic, photocatalytic properties of one-dimensional Ag@Fe3O4-TiO. Appl. Surf. Sci. 2017, 392, 268–276. [Google Scholar] [CrossRef]
- Cong, S.; Tian, Y.; Li, Q.; Zhao, Z.; Geng, F. Single-crystalline tungsten oxide quantum dots for fast pseudocapacitor and electrochromic applications. Adv. Mater. 2014, 26, 4260–4267. [Google Scholar] [CrossRef]
- Wang, M.; Sun, L.; Cai, J.; Huang, P.; Su, Y.; Lin, C. A facile hydrothermal deposition of ZnFe2O4 nanoparticles on TiO2 nanotube arrays for enhanced visible light photocatalytic activity. J. Mater. Chem. A 2013, 1, 12082–12087. [Google Scholar] [CrossRef]
- Delekar, S.D.; Yadav, H.M.; Achary, S.N.; Meena, S.S.; Pawar, S.H. Structural refinement and photocatalytic activity of Fe-doped anatase TiO2 nanoparticles. Appl. Surf. Sci. 2012, 263, 536–545. [Google Scholar] [CrossRef]
- Theerthagiri, J.; Senthil, R.A.; Malathi, A.; Selvi, A.; Madhavan, J.; Ashokkumar, M. Synthesis and characterization of a CuS-WO3 composite photocatalyst for enhanced visible light photocatalytic activity. RSC Adv. 2015, 5, 52718–52725. [Google Scholar] [CrossRef]
- Ba-abbad, M.M.; Kadhum, A.A.H.; Mohamad, A.B.; Takriff, M.S. 7064871.Pdf. Int. J. Electrochem. Sci. 2012, 7, 4871–4888. [Google Scholar]
- Norzaee, S.; Bazrafshan, E.; Djahed, B.; Kord Mostafapour, F.; Khaksefidi, R. UV Activation of Persulfate for Removal of Penicillin G Antibiotics in Aqueous Solution. Sci. World J. 2017, 2017. [Google Scholar] [CrossRef]
- Kamranifar, M.; Allahresani, A.; Naghizadeh, A. Synthesis and characterizations of a novel CoFe2O4@CuS magnetic nanocomposite and investigation of its efficiency for photocatalytic degradation of penicillin G antibiotic in simulated wastewater. J. Hazard. Mater. 2019, 366, 545–555. [Google Scholar] [CrossRef]
- Dehghani, M.; Nasseri, S.; Ahmadi, M.; Samaei, M.R.; Anushiravani, A. Removal of penicillin G from aqueous phase by Fe+3-TiO2/UV-A process. J. Environ. Heal. Sci. Eng. 2014, 12, 1–7. [Google Scholar] [CrossRef]
- Ahmadpour, N.; Sayadi, M.H.; Homaeigohar, S. A hierarchical Ca/TiO2/NH2-MIL-125 nanocomposite photocatalyst for solar visible light induced photodegradation of organic dye pollutants in water. RSC Adv. 2020, 10, 29808–29820. [Google Scholar] [CrossRef]
- Ye, S.; Yan, M.; Tan, X.; Liang, J.; Zeng, G.; Wu, H.; Song, B.; Zhou, C.; Yang, Y.; Wang, H. Facile assembled biochar-based nanocomposite with improved graphitization for efficient photocatalytic activity driven by visible light. Appl. Catal. B Environ. 2019, 250, 78–88. [Google Scholar] [CrossRef]
- Nasseh, N.; Al-Musawi, T.J.; Miri, M.R.; Rodriguez-Couto, S.; Hossein Panahi, A. A comprehensive study on the application of FeNi3@SiO2@ZnO magnetic nanocomposites as a novel photo-catalyst for degradation of tamoxifen in the presence of simulated sunlight. Environ. Pollut. 2020, 261, 114127. [Google Scholar] [CrossRef]
- Sayadi, M.H.; Sobhani, S.; Shekari, H. Photocatalytic degradation of azithromycin using GO@Fe3O4/ZnO/SnO2 nanocomposites. J. Clean. Prod. 2019, 232, 127–136. [Google Scholar] [CrossRef]
- Popa, A.; Stefan, M.; Toloman, D.; Pana, O.; Mesaros, A.; Leostean, C.; Macavei, S.; Marincas, O.; Suciu, R.; Barbu-Tudoran, L. Fe3O4-TiO2: Gd nanoparticles with enhanced photocatalytic activity and magnetic recyclability. Powder Technol. 2018, 325, 441–451. [Google Scholar] [CrossRef]
- Meng, X.; Zhuang, Y.; Tang, H.; Lu, C. Hierarchical structured ZnFe2O4@SiO2@TiO2 composite for enhanced visible-light photocatalytic activity. J. Alloys Compd. 2018, 761, 15–23. [Google Scholar] [CrossRef]
- Hsiao, P.H.; Li, T.C.; Chen, C.Y. ZnO/Cu2O/Si Nanowire Arrays as Ternary Heterostructure-Based Photocatalysts with Enhanced Photodegradation Performances. Nanoscale Res. lett. 2019, 14, 244. [Google Scholar] [CrossRef] [PubMed]
- Tang, C.H.; Chen, K.Y.; Chen, C.Y. Solution-processed ZnO/Si based heterostructures with enhanced photocatalytic performance. New J. Chem. 2018, 42, 13797–13802. [Google Scholar] [CrossRef]
- Zheng, Y.; Liu, D.; Liu, S.; Xu, S.; Yuan, Y.; Xiong, L. Kinetics and mechanisms of p-nitrophenol biodegradation by Pseudomonas aeruginosa HS-D. J. Environ. Sci. 2009, 21, 1194–1199. [Google Scholar] [CrossRef]
- Homaeigohar, S.; Botcha, N.K.; Zarie, E.; Elbahri, M. Ups and downs of water photodecolorization by nanocomposite polymer nanofibers. Nanomaterials 2019, 9, 250. [Google Scholar] [CrossRef]
- Rajamanickam, D.; Shanthi, M. Photocatalytic degradation of an organic pollutant by zinc oxide—solar process. Arab. J. Chem. 2016, 9, S1858–S1868. [Google Scholar] [CrossRef]
- Xu, L.; Yang, L.; Johansson, E.M.J.; Wang, Y.; Jin, P. Photocatalytic activity and mechanism of bisphenol a removal over TiO2−x/rGO nanocomposite driven by visible light. Chem. Eng. J. 2018, 350, 1043–1055. [Google Scholar] [CrossRef]
- Wang, J.; Tang, L.; Zeng, G.; Deng, Y.; Liu, Y.; Wang, L.; Zhou, Y.; Guo, Z.; Wang, J.; Zhang, C. Atomic scale g-C3N4/Bi2WO6 2D/2D heterojunction with enhanced photocatalytic degradation of ibuprofen under visible light irradiation. Appl. Catal. B Environ. 2017, 209, 285–294. [Google Scholar] [CrossRef]
- Xi, G.; Yue, B.; Cao, J.; Ye, J. Fe3O4/WO3 hierarchical core–shell structure: High-performance and recyclable visible-light photocatalysis. Chem. A Eur. 2011, 17, 5145–5154. [Google Scholar] [CrossRef] [PubMed]
- Su, R.; Tiruvalam, R.; He, Q.; Dimitratos, N.; Kesavan, L.; Hammond, C.; Lopez-Sanchez, J.A.; Bechstein, R.; Kiely, C.J.; Hutchings, G.J.; et al. Promotion of phenol photodecomposition over TiO2 Using Au, Pd, and Au-Pd nanoparticles. ACS Nano. 2012, 6, 6284–6292. [Google Scholar] [CrossRef] [PubMed]
- Rupa, A.V.; Manikandan, D.; Divakar, D.; Sivakumar, T. Effect of deposition of Ag on TiO2 nanoparticles on the photodegradation of Reactive Yellow. J. Hazard. Mater. 2007, 147, 906–913. [Google Scholar] [CrossRef] [PubMed]
- Mlalila, N.G.; Swai, H.S.; Hilonga, A.; Kadam, D.M. Antimicrobial dependence of silver nanoparticles on surface plasmon resonance bands against Escherichia coli. Nanotechnol. Sci. Appl. 2017, 10, 1–9. [Google Scholar] [CrossRef]
- Pant, H.R.; Pant, B.; Sharma, R.K.; Amarjargal, A.; Kim, H.J.; Park, C.H.; Tijing, L.D.; Kim, C.S. Antibacterial and photocatalytic properties of Ag/TiO2/ZnO nano-flowers prepared by facile one-pot hydrothermal process. Ceram. Int. 2013, 39, 1503–1510. [Google Scholar] [CrossRef]

Publisher’s Note: MDPI stays neutral with regard to jurisdictional claims in published maps and institutional affiliations. |
© 2021 by the authors. Licensee MDPI, Basel, Switzerland. This article is an open access article distributed under the terms and conditions of the Creative Commons Attribution (CC BY) license (http://creativecommons.org/licenses/by/4.0/).
Share and Cite
Sayadi, M.H.; Ahmadpour, N.; Homaeigohar, S. Photocatalytic and Antibacterial Properties of Ag-CuFe2O4@WO3 Magnetic Nanocomposite. Nanomaterials 2021, 11, 298. https://doi.org/10.3390/nano11020298
Sayadi MH, Ahmadpour N, Homaeigohar S. Photocatalytic and Antibacterial Properties of Ag-CuFe2O4@WO3 Magnetic Nanocomposite. Nanomaterials. 2021; 11(2):298. https://doi.org/10.3390/nano11020298
Chicago/Turabian StyleSayadi, Mohammad Hossein, Najmeh Ahmadpour, and Shahin Homaeigohar. 2021. "Photocatalytic and Antibacterial Properties of Ag-CuFe2O4@WO3 Magnetic Nanocomposite" Nanomaterials 11, no. 2: 298. https://doi.org/10.3390/nano11020298
APA StyleSayadi, M. H., Ahmadpour, N., & Homaeigohar, S. (2021). Photocatalytic and Antibacterial Properties of Ag-CuFe2O4@WO3 Magnetic Nanocomposite. Nanomaterials, 11(2), 298. https://doi.org/10.3390/nano11020298

